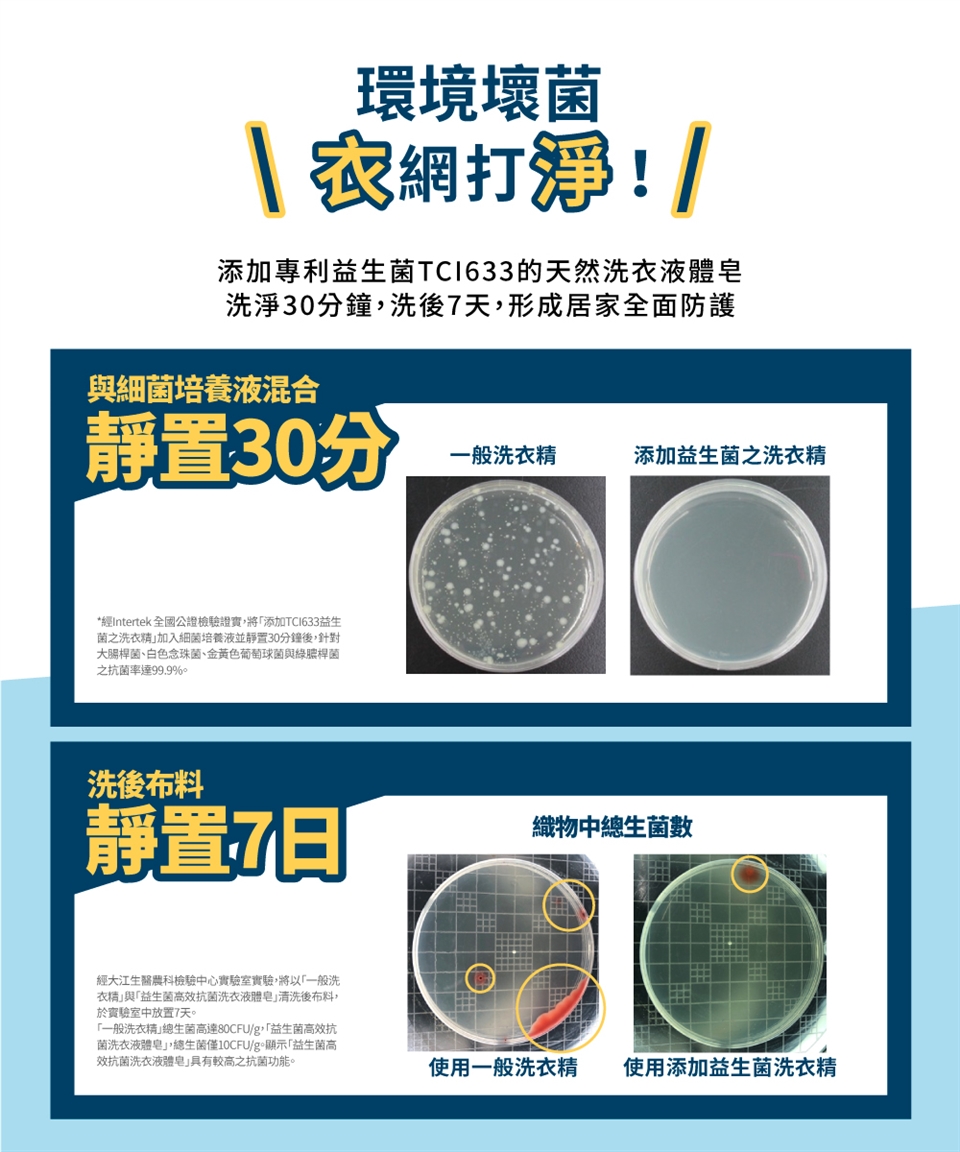

商品詳細介紹

體驗說明
主商品:
1.益生菌高效抗菌洗衣液體皂1200g*1瓶(不可體驗)
1.益生菌高效抗菌洗衣液體皂補充包 800g*5包(開放一包體驗)
贈品:
1. 水晶肥皂奉天宮金虎爺手工皂90g*1(不開放體驗)
2. Strawberry益菌棉護墊 15cm 24片*8包(開放一包體驗)
1.益生菌高效抗菌洗衣液體皂1200g*1瓶(不可體驗)
1.益生菌高效抗菌洗衣液體皂補充包 800g*5包(開放一包體驗)
贈品:
1. 水晶肥皂奉天宮金虎爺手工皂90g*1(不開放體驗)
2. Strawberry益菌棉護墊 15cm 24片*8包(開放一包體驗)
使用方法說明
適用於洗滌棉、麻、人造纖維、混紡等織品衣物
注意事項
置於陰涼乾燥處,避免日光直射,並置於六歲以下兒童無法取得處。